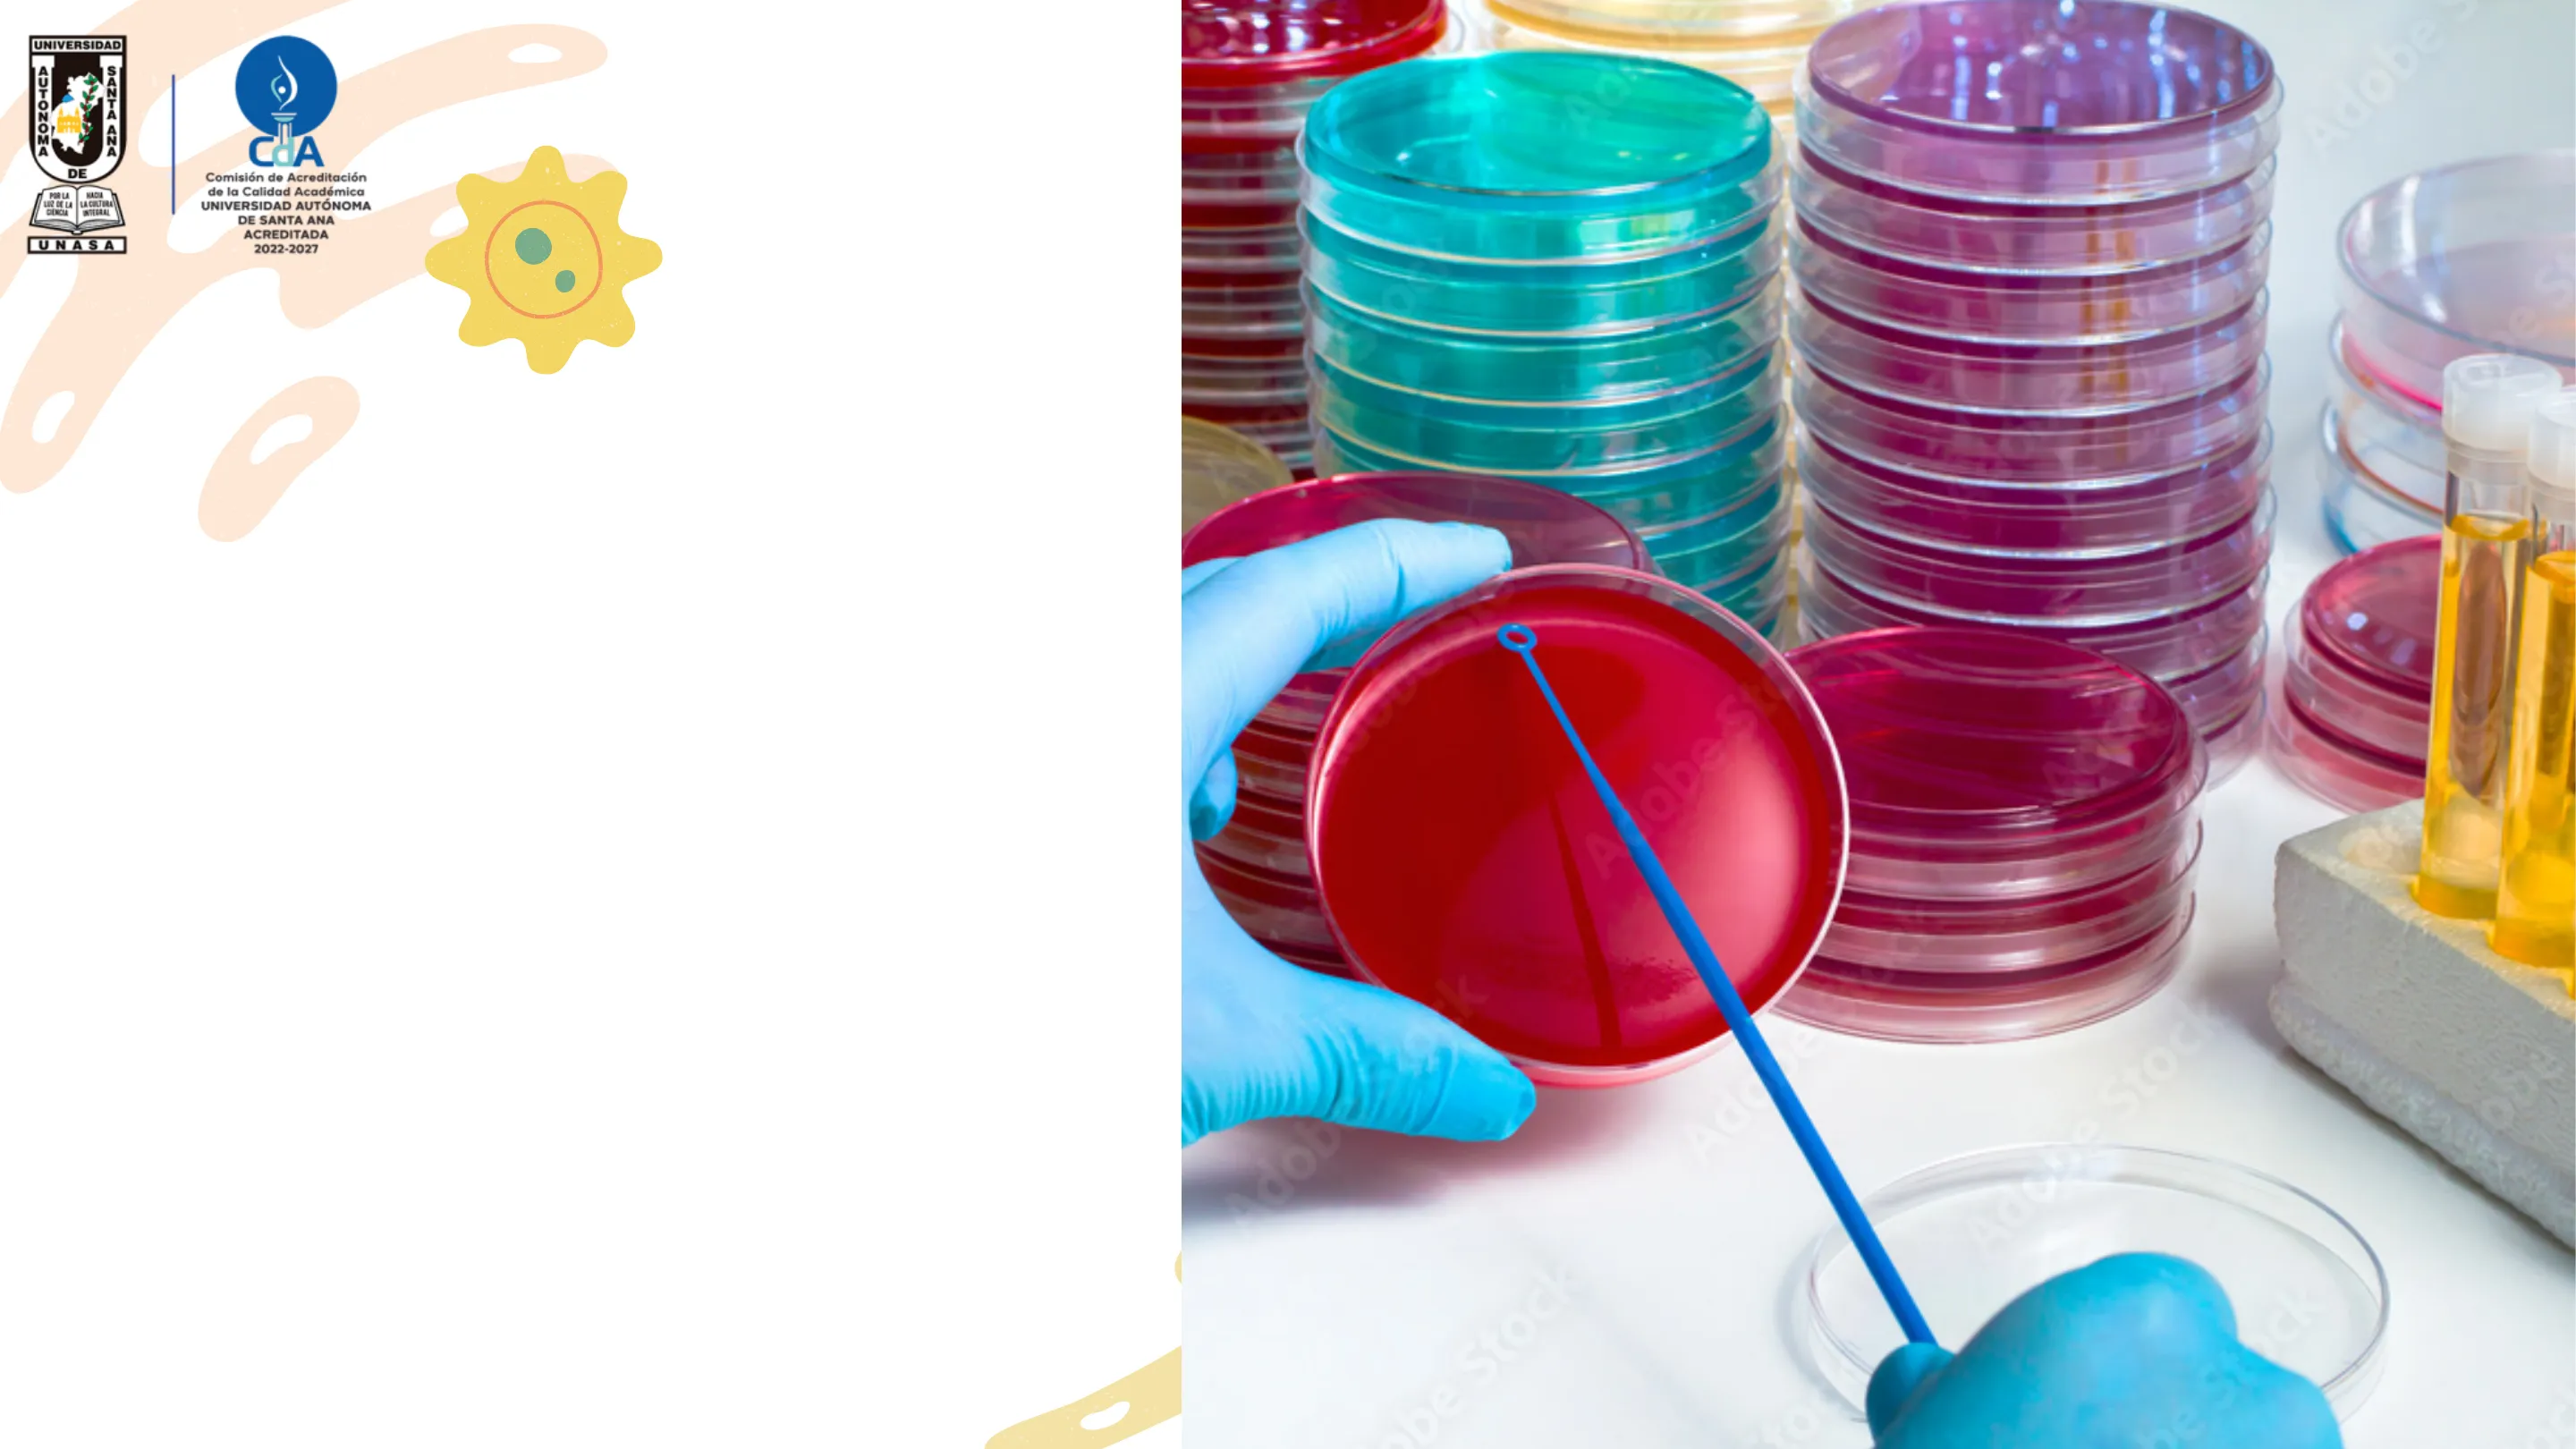
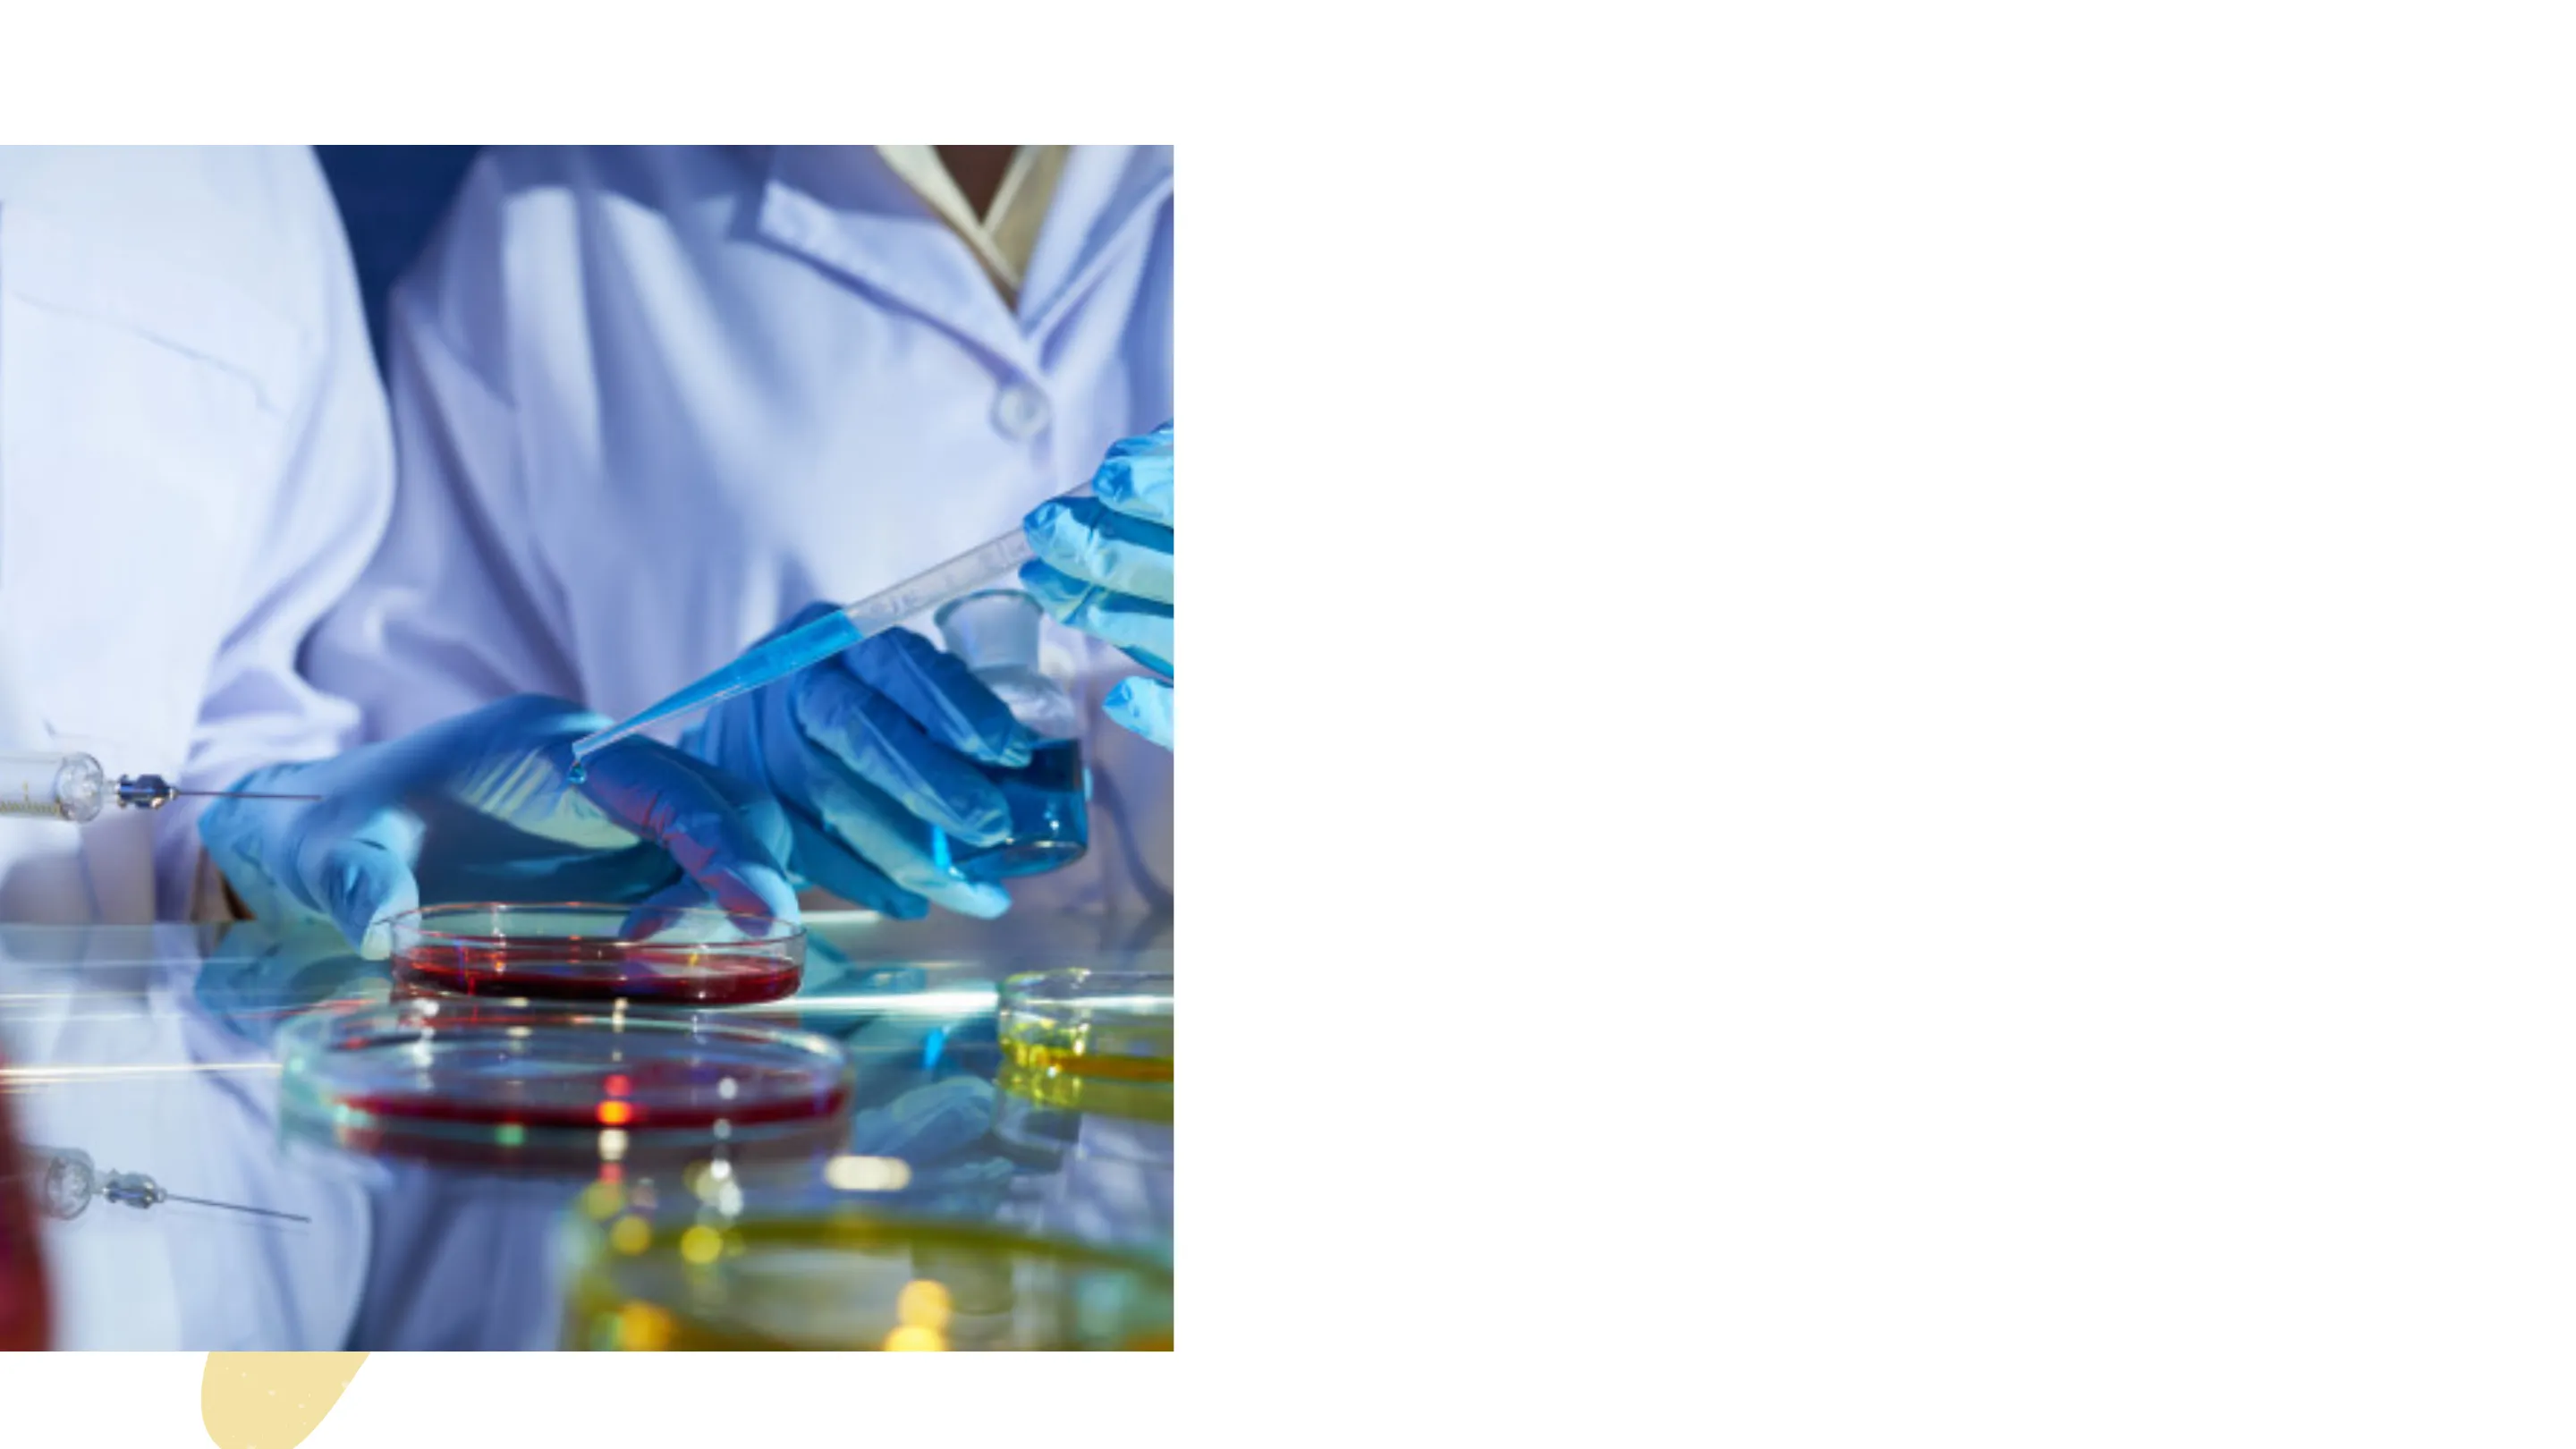

Técnica Instrumental: Medios de Cultivo en Microbiología de UASA
Diapositivas de la Universidad Autónoma de Santa Ana sobre Técnica Instrumental Medios de Cultivo. El Pdf, enfocado en Biología para nivel universitario, detalla la composición y aplicaciones de medios como Agar Sangre, Agar Chocolate y Agar C.L.E.D., ofreciendo un soporte didáctico conciso y visualmente claro.
Ver más34 páginas

Visualiza gratis el PDF completo
Regístrate para acceder al documento completo y transformarlo con la IA.
Vista previa
UNIVERSIDAD CỦA DE POR LA LUR DE LA LA CULTURA UNASA
Comisión de Acreditación de la Calidad Académica
UNIVERSIDAD AUTÓNOMA DE SANTA ANA
ACREDITADA 2022-2027
TÉCNICA INSTRUMENTAL
MEDIOS DE CULTIVO
obest A Adc CK Adobe y Adobe Stock be StockContenidos.
- Bienvenida
- Reflexión.
- Desarrollo de la clase.
- Aplicación de conocimientos.
"Las personas no son recordadas por el número de veces que fracasan, sino por el número de veces que tienen éxito" Thomas Alva Edison (1847-1931) Inventor y Científico Estadounidense
Secretaria de Asuntos Académicos Maria Rosa Pança de Miller
Introducción a los Medios de Cultivo
Uno de los sistemas más importantes para la identificación de microorganismos es observar su crecimiento en sustancias alimenticias artificiales preparadas en el laboratorio. El material alimenticio en el que crecen los microorganismos es el Medio de Cultivo y el crecimiento de los microorganismos es el Cultivo. Se han preparado más de 10.000 medios de cultivo diferentes.
Para que las bacterias crezcan adecuadamente en un medio de cultivo artificial debe reunir una serie de condiciones como son: temperatura, grado de humedad y presión de oxígeno adecuadas, así como un grado correcto de acidez o alcalinidad. Un medio de cultivo debe contener los nutrientes y factores de crecimiento necesarios y debe estar exento de todo microorganismo contaminante.
La mayoría de las bacterias patógenas requieren nutrientes complejos similares en composición a los líquidos orgánicos del cuerpo humano. Por eso, la base de muchos medios de cultivo es una infusión de extractos de carne y Peptona a la que se añadirán otros ingredientes.
El agar es un elemento solidificante muy empleado para la preparación de medios de cultivo. Se licúa completamente a la temperatura del agua hirviendo y se solidifica al enfriarse a 40 grados. Con mínimas excepciones no tiene efecto sobre el crecimiento de las bacterias y no es atacado por aquellas que crecen en él La Gelatina es otro agente solidificante pero se emplea mucho menos ya que bastantes bacterias provocan su licuación. .
En los diferentes medios de cultivo se encuentran numerosos materiales de enriquecimiento como hidratos de carbono, suero, sangre completa, bilis, etc. Los hidratos de Carbono se adicionan por dos motivos fundamentales: para incrementar el valor nutritivo del medio y para detectar reacciones de fermentación de los microorganismos que ayuden a identificarlos. El suero y la sangre completa se añaden para promover el crecimiento de los microorganismos menos resistentes.
También se añaden colorantes que actúan como indicadores para detectar, por ejemplo, la formación de ácido o como inhibidores del crecimiento de unas bacterias y no de otras (el Rojo Fenol se usa como indicador ya que es rojo en pH básico y amarillo en pH ácido. La Violeta de Genciana se usa como inhibidor ya que impide el crecimiento de la mayoria de las bacterias Grampositivas).
Condiciones generales para el cultivo de microorganismos
El desarrollo adecuado de los microorganismos en un medio de cultivo se ve afectado por una serie de factores de gran importancia y que, en algunos casos, son ajenos por completo al propio medio.
Disponibilidad de nutrientes adecuados
01 Un medio de cultivo adecuado para la investigación microbiológica ha de contener, como mínimo, carbono, nitrógeno, azufre, fósforo y sales inorgánicas
Consistencia adecuada del medio
02 Partiendo de un medio líquido podemos modificar SU consistencia añadiendo productos como albúmina, gelatina o agar, con lo que obtendríamos medios en estado semisólido o sólido.
Presencia o ausencia de oxígeno y otros gases
03 Gran cantidad de bacterias pueden crecer en una atmósfera con tensión de oxígeno normal. Algunas pueden obtener el oxígeno directamente de variados sustratos.
Condiciones adecuadas de humedad
04 Un nivel mínimo de humedad, tanto en el medio como en la atmósfera, es imprescindible para un buen desarrollo de las células vegetativas microbianas en los cultivos.
Condiciones generales para el cultivo de microorganismos
Luz ambiental
05 La mayoría de los microorganismos crecen mucho mejor en la oscuridad que en presencia de luz solar. Hay excepciones evidentes como sería el caso de los microorganismos fotosintéticos.
PH
06 La concentración de iones hidrógeno es muy importante para el crecimiento de los microorganismos. La mayoría de ellos se desarrollan mejor en medios con un PH neutro, aunque los hay que requieren medios más o menos ácidos.
Temperatura
07 Los microorganismos mesófilos crecen de forma óptima a temperaturas entre 15 y 43ºC. Otros como los psicrófilos crecen a 0°℃ y los termófilos a 80℃ o incluso a temperaturas superiores (hipertemófilos).
Esterilidad del medio
08 Todos los medios de cultivo han de estar perfectamente estériles para evitar la aparición de formas de vida que puedan alterar, enmascarar o incluso impedir el crecimiento microbiano normal del o de los especimenes inoculados en dichos medios. El sistema clásico para esterilizar los medios de cultivo es el autoclave (que utiliza vapor de agua a presión como agente esterilizante)
Evolución de medios de cultivo
01 La primera noticia de la utilización de medios de cultivo nos llega del micólogo Brefeld, que consiguió aislar y cultivar esporas de hongos en medios sólidos realizados a base de gelatina.
02 Koch realizó sus investigaciones utilizando en un primer momento rodajas de patata como soporte nutritivo sólido, pero no tardó en recurrir al caldo de carne líquido, diseñado por Loeffler, al que, en 1881, añadió gelatina, logrando un medio sólido transparente ideal para la observación de la morfología macroscópica de las colonias microbianas.
03 En el año 1882 tiene lugar uno de los grandes avances de la microbiología en relación con los medios de cultivo: el médico alemán Walter Hesse introduce el agar-agar (polisacárido extraído de algas rojas) como solidificante.
04 En 1887 un ayudante de Koch llamado Petri, comienza a utilizar placas de cristal planas, que se llaman desde entonces placas de Petri, para sustituir a las clásicas bandejas de vidrio cubiertas con campanas que se usaban hasta entonces.
05 Beijerinck y Winogradsky, que desde de 1888 realizaron sus investigaciones sobre las bacterias quimioautótrofas (utilización de nitrógeno y azufre sobre todo) tuvieron gran importancia en el desarrollo de los medios selectivos y de enriquecimiento.
06 En 1892 Würtz impulsó el uso de los medios diferenciales, incorporando indicadores de pH a la composición de ciertos medios con lo cual se podía observar la producción de ácidos en la fermentación en ciertos microorganismos.
TIPOS BÁSICOS DE MEDIOS DE CULTIVO
POR SU ESTADO FÍSICO
01 SÓLIDOS 02 LÍQUIDOS 03 SEMISÓLIDOS
Una forma muy útil de poder aislar, identificar y conservar los microorganismos es mediante el uso de medios de cultivo, inicialmente ideados por Pasteur (que 9 como ya sabemos se considera el padre de la microbiología), quien se dio cuenta que los microorganismos podían crecer en soluciones que tuvieran azúcar y una fuente de nitrógeno.
POR SU ESTADO FÍSICO: Sólidos y Líquidos
W: En los medios de cultivo sólidos y líquidos, debe haber una buena cantidad de nutrientes que faciliten el crecimiento bacteriano.
¿Cuál es la diferencia? La diferencia radica en la presencia de una sustancia que se llama Agar o "Agar-Agar" y que es la encargada de darle la solidez y consistencia al medio. Esta sustancia proviene, principalmente, de un alga llamada Gelidium, aunque muchos otros géneros pueden servir como fuente de este polisacárido (es decir, un azúcar grande formado por la unión de azúcares pequeños).
¿Cómo se obtiene del alga? Se toman sus semillas, se lavan, se secan, se realizan procesos de extracción, filtración, purificación y desecación para que queden hojuelas o polvo y luego si adicionarla al medio de cultivo.
POR SU ESTADO FÍSICO: Ventajas y Semisólidos
La ventaja fundamental de usar un medio de cultivo líquido, es que permite que crezcan bacterias que se encuentran en muy poca cantidad, es decir, cuya concentración es muy baja en la muestra que estemos analizando. Para el caso del medio de cultivo sólido, la ventaja radica en que permite detectar los diferentes tipos de bacterias que puedan encontrarse en una sola muestra. Entonces el usar uno u otro medio de cultivo dependerá de lo que busquemos o queramos: aislar una bacteria que se encuentre en cantidades muy pequeñas (medio líquido) o todas las bacterias que puedan haber en una muestra (medio sólido)
Medios semisólidos Se preparan a partir de los medios líquidos, agregando a éstos un agente solidificante en una proporción menor que para preparar medios sólidos. Uno de sus usos es la investigación de la movilidad de las bacterias.
POR SU UTILIZACIÓN
01 MEDIOS COMUNES 02 MEDIOS DE ENRIQUECIMIENTO 03 MEDIOS SELECTIVOS 04 MEDIOS INHIBIDORES 05 MEDIOS DIFERENCIALES 06 MEDIOS DE IDENTIFICACIÓN 07 MEDIOS DE MULTIPLICACIÓN 08 MEDIOS DE CONSERVACIÓN 09 MEDIOS DE TRANSPORTE
Clasificación de acuerdo a su utilización
Medios comunes
Son aquellos que poseen los componentes mínimos para que pueda producirse el crecimiento de bacterias que no necesiten requerimientos especiales. El medio más conocido de este grupo es el agar nutritivo o agar común, que resulta de la adición de agar al caldo nutritivo. Otros representantes de este grupo son el agar tripticase de soja, el agar Columbia, etc.
Medios de enriquecimiento
Son aquellos que, además de las sustancias nutritivas normales, incorporan una serie de factores indispensables para el crecimiento de microorganismos exigentes. Este enriquecimiento se hace por adición de sangre u otros productos biológicos (sangre, suero, leche, huevo, bilis, etc.) que aportan dichos factores.
Medios selectivos
Son medios utilizados para favorecer el crecimiento de ciertas bacterias contenidas en una población polimicrobiana. El fundamento de estos medios consiste en facilitar nutricionalmente el crecimiento de una población microbiana específica. Un ejemplo de medio selectivo es el caldo selenito, que se utiliza para favorecer el crecimiento de salmonellas y frenar el del resto de enterobacterias.